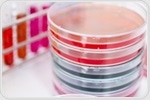
Personalized, precision approach can reverse memory loss in Alzheimer’s patients

|
|
|
| |

|
|
| |
The latest Alzheimer's disease news from News Medical |
|
|
|
|
|
 | | |  Researchers at Karolinska Institutet in Sweden have imaged tau protein in the brains of living patients with Alzheimer's disease. Researchers at Karolinska Institutet in Sweden have imaged tau protein in the brains of living patients with Alzheimer's disease. | | | | |  Neurons in the brains of such people are being depleted gradually and inevitably, resulting in the characteristic loss of cognitive function and memory. Neurons in the brains of such people are being depleted gradually and inevitably, resulting in the characteristic loss of cognitive function and memory. | | | | |  Two decades or more before symptoms arise, plaques of a sticky protein called amyloid begin forming in the brains of people later diagnosed with Alzheimer's disease. Two decades or more before symptoms arise, plaques of a sticky protein called amyloid begin forming in the brains of people later diagnosed with Alzheimer's disease. | | | | | Cognitive decline is a major concern of the aging population. Already, Alzheimer's disease affects approximately 5.4 million Americans and 30 million people globally. Without effective prevention and treatment, the prospects for the future are bleak. Cognitive decline is a major concern of the aging population. Already, Alzheimer's disease affects approximately 5.4 million Americans and 30 million people globally. Without effective prevention and treatment, the prospects for the future are bleak. | | | | |  Even though specific amyloids are found to have a biological function, the formation of amyloids is often linked to Parkinson’s and Alzheimer’s diseases. Even though specific amyloids are found to have a biological function, the formation of amyloids is often linked to Parkinson’s and Alzheimer’s diseases. | |
|
|
|
|
|